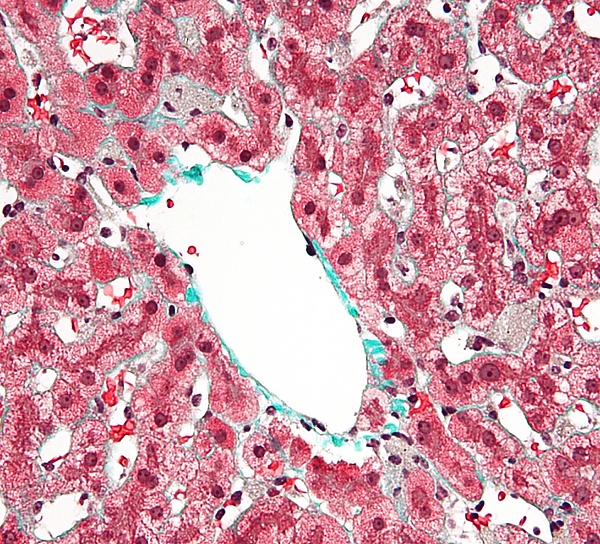

Клетки Купфера
Кле́тки Ку́пфера — специализированные клетки, располагающиеся в люмене (внутреннем пространстве) синусоид печени и прикреплённые к синусоидальным эндотелиальным клеткам, образующим стенки кровеносных сосудов. Клетки Купфера — наиболее многочисленные резидентные макрофаги в печени человека, они входят в состав системы мононуклеарных макрофагов (ретикуло-эндотелиальной системы). Через воротную вену в печень из пищеварительного тракта поступают кишечные бактерии, бактериальные эндотоксины, которые в печени первым делом сталкиваются с клетками Купфера, образующими первую линию иммунной защиты печени. Нарушения функционирования клеток Купфера сопровождают многие заболевания печени, такие как алкогольная болезнь печени, вирусные гепатиты, внутрипечёночный холестаз, стеатогепатит, цирроз печени, а также при отторжении трансплантата печёночной ткани[1][2].
Строение
Клетки Купфера имеют амёбоидную форму и прикреплены к синусоидальным эндотелиальным клеткам. На поверхности клеток Купфера имеются микроворсинки, псевдоподии и ламеллоподии, расположенные во всех направлениях. Микроворсинки и псевдоподии задействованы в поглощении частиц. В цитоплазме клеток Купфера располагаются рибосомы, аппарат Гольджи, эндоплазматический ретикулум (в особенности, шероховатый), центриоли, микротрубочки и микрофиламенты. Ядро яйцевидное, может быть подразделено на доли. В органеллах клеток Купфера присутствует пероксидазная активность. Клетки Купфера локализованы и в центрилобулярной, и в перипортальной части долек печени, однако их функции в этих регионах различны. Перипортальные клетки Купфера более крупные, содержат больше лизосом и более активны в плане фагоцитоза, а центрилобулярные клетки Купферы специализированы на генерации супероксид-радикала. Внутри клеток Купфера имеются скэвенджер-рецепторы SR-AI/II. Они участвуют в распознавании и связывании липида A в составе молекул липополисахарида и липотейхоевых кислот. Липополисахарид является эндотоксином, входящим в состав клеточных стенок грамотрицательных бактерий, а липотейхоевые кислоты присутствуют в клеточных стенках грамположительных бактерий[4].
Развитие
Развитие клеток Купфера начинается в желточном мешке, где они дифференцируются в зародышевые макрофаги. После выхода в кровоток они мигрируют в печень плода, где и оседают и завершают дифференцировку в клетки Купфера[5].
В печени имеется две группы макрофагов: клетки Купфера, происходящие от кроветворных клеток-предшественниц, развивающихся в желточном мешке, и макрофаги, происходящие от моноцитов, которые образуются в красном костном мозге от гемопоэтических стволовых клеток и по кровотоку попадают в печень. Макрофаги второй группы дифференцируются в макрофаги под влиянием микросреды, а клетки Купфера являются полностью самостоятельной дифференцированной популяцией клеток, способных к локальной пролиферации. Для дифференцировки клеток Купфера требуются многие факторы роста, важнейшим из которых являются колониестимулирующие факторы[6][2].
Функции
Среднее время жизни клеток Купфера составляет 3,8 суток. Их главная функция — удаление инородного дебриса и частиц, поступающих в печень по воротной вене. Крупные частицы, возможно, поглощаются клетками Купфера с помощью фагоцитоза, а мелкие — посредством пиноцитоза[4]. Клетки Купфера входят в систему врождённого иммунитета и играют важную роль в защите организма, а также метаболизируют различные вещества липидной природы, расщепляют белковые комплексы и мелкие частицы. Они также удаляют из кровотока апоптотические клетки. Количество клеток Купфера в печени постоянно и поддерживается с помощью апоптоза и фагоцитоза соседними клетками Купфера. Они обладают пролиферативным потенциалом и могут восстанавливать свою численность, в отличие от макрофагов, происходящих от моноцитов, которые неспособны к пролиферации. По функциям клетки Купфера гетерогенны, и клетки из разных локаций могут отличаться функционально. Например, клетки Купфера из зоны 1 дольки печени более активны, чем таковые из зоны 3, вероятно, в связи с тем, что клетки из зоны 1 больше сталкиваются с чужеродными частицами и веществами. Клетки Купфера могут продуцировать провоспалительные цитокины, в частности, фактор некроза опухоли α (TNFα) в M1-состоянии, и противовоспалительные цитокины, например, IL-10, в M2-состоянии, кислородные радикалы и протеазы. Выделение этих соединений может приводить к повреждениям печени[4]. Кроме того, клетки Купфера несут рецепторы комплемента иммуноглобулинового семейства (CRIg), и мыши, лишённые CRIg, неспособны разрушать патогенные клетки, покрытые компонентами системы комплемента. CRIg консервативны у человека и мышей и играют важную роль в работе врождённого иммунитета[7].
Клиническое значение
Клетки Купфера задействованы в патогенезе острой и хронической алкогольной болезни печени, которая может проявляться в виде стеатоза, стеатогепатита, фиброза и цирроза. Активация клеток Купфера при чрезмерном употреблении алкоголя приводит к ранним повреждениям печени, которые часто встречаются при хроническом алкоголизме. В этом случае на клетках Купфера активируются рецепторы TLR4 и CD14, которые предназначены для распознавания и интернализации эндотоксина. Активация этих рецепторов приводит к избыточному поглощению эндотоксина, происходящего от кишечных бактерий[8][4], и последующему запуску транскрипции гена, кодирующего TNFα, и продукции супероксида. Продуцируемый клетками Купфера TNFα действует на клетки Ито в печени, что приводит к запуску биосинтеза коллагена и фиброзу, который, в конечном итоге, приводит к развитию цирроза печени[9].
При сепсисе клетки Купфера отвечают за большую часть повреждений печени. Макрофаги печени активируются и продуцируют IL-1 и TNFα, которые, в свою очередь, активируют лейкоциты и синусоидальные эндотелиальные клетки, начинающие экспрессировать ICAM-1. В итоге эндотелий сосудов печени разрушается под действием протеаз, кислородных радикалов и других веществ, продуцируемых лейкоцитами[8][4].
История изучения
Клетки Купфера были открыты в 1876 году немецким анатомом Карлом Вильгельмом Купфером (1829—1902), в честь которого впоследствии и получили своё название[10]. Сам Купфер назвал их Sternzellen (звёздчатые клетки), однако он посчитал, что они являются частью эндотелия кровеносных сосудов печени и происходят от эндотелиоцитов. В 1898 году Тадеуш Брович показал, что клетки Купфера в действительности являются макрофагами[11][12].